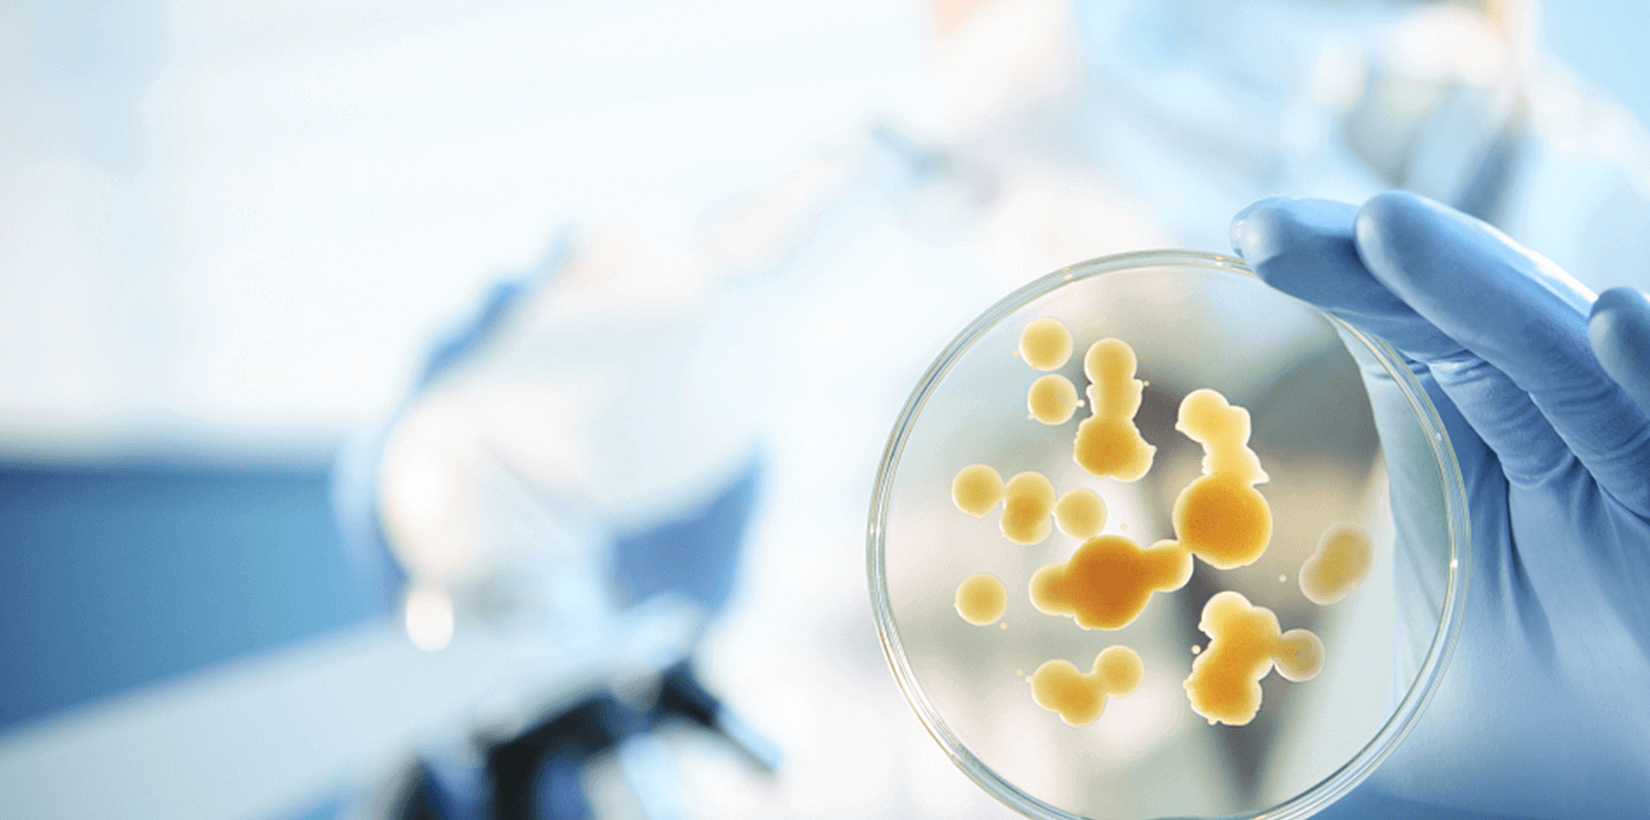

全球首家专注于
癌症精准医疗的原创型
高新技术平台
 微流控纯物理稀有细胞捕捉技术
微流控纯物理稀有细胞捕捉技术
-
全球首家专注于精准医疗的原创型
高新技术平台
我们专注于精准医疗领域的原创性高新技术研发,聚焦稀有细胞的分离、富集与功能化应用。
依托自主开发的 新一代惯性微流体平台,我们能够在无需抗体标记的条件下,从血液、脑脊液及多种体液样本中高纯度获取多类型稀有细胞,
包括肿瘤细胞、免疫细胞及干细胞等,完整保留其形态和活性特征。
我们坚信,精准医疗的未来,始于对生命最细微单元的深入理解。
video
公司宣传视频
慢病化、长生存个体化精准医疗让人们不再谈癌色变

筛选95%以上高活性真实癌症细胞,助力精
准检测与高效培养,打通癌症早筛与个体化
治疗的新道路。
准检测与高效培养,打通癌症早筛与个体化
治疗的新道路。
医疗器械产品
从靶点验证到PDX药效验证:您的一站式
转化医学合作伙伴
转化医学合作伙伴




 肿瘤早期筛查
肿瘤早期筛查